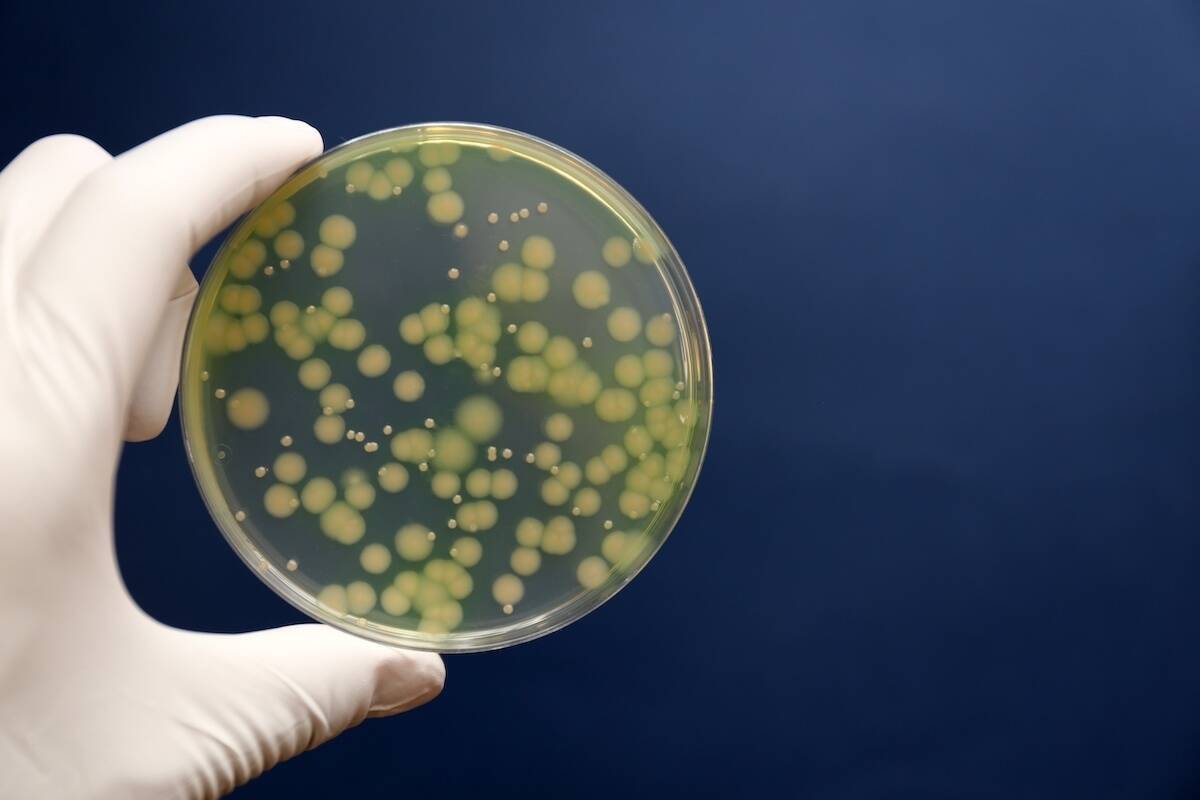

授業で使ったり、学校にあったモノの名前を当てるクイズです。
なつかしのアレ、覚えてますか?
理科の実験で使ったアレの名前を当てて!

●ヒントは
↓
↓
↓
↓
↓
↓
↓
↓
↓
<ヒント>
■ャー■
●正解は
↓
↓
↓
↓
↓
↓
↓
↓
↓
<正解>
シャーレ
でした!
わかりましたか?
ぜひ他のクイズにも挑戦して、脳を活性化させましょう!
他のクイズにも挑戦!



<難読地名クイズ/漢字分割クイズ/漢字探しクイズ/バラバラ四字熟語/穴あき人名ルーレット/脳トレ計算クイズ/脳トレひらめきワード/単語パズル/シルエットクイズ/角度当て/10にするクイズ/イライラする間違い探し/スリーヒントクイズ/クイズ!都道府県ランキング/箱の数当てクイズ/心理テスト>
編集部おすすめ